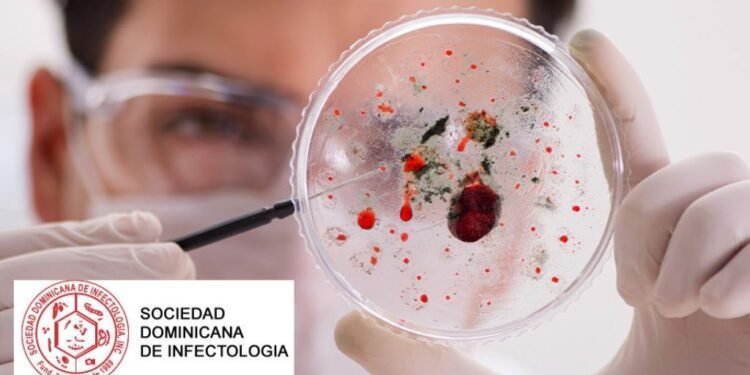
Sociedad Infectología emite recomendaciones por alerta sarampión

La Sociedad Dominicana de Infectología (SDI), con el objetivo de dar respuesta a la alerta emitida por la Organización Panamericana de la Salud (OPS) y el Ministerio de Salud Pública (MSP) en días pasados sobre el virus de sarampión, emitió una serie de recomendaciones para evitar la propagación del mismo.
Estas recomendaciones consisten en : la actualización de los esquemas de vacunación tanto en niños como en adultos sin evidencia de inmunidad, llamó también a estar atentos a síntomas como: fiebre, congestión nasal, malestar general, conjuntivitis, secreción nasal, así como alergia que inicia en la cara y se distribuye por todo el cuerpo.
Llamó a acudir a los centros de manera temprana ante la presentación de cualesquiera de estos síntomas ya que el sarampión es un virus de muy rápida propagación. De igual forma llamó a considerar que otros virus poseen varios de los síntomas y tienen un abordaje diferente.